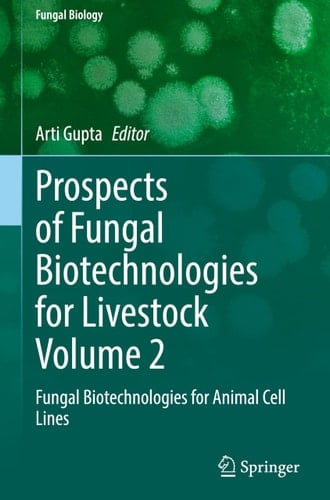
Prospects of Fungal Biotechnologies for Livestock Volume 2 Fungal Biotechnologies for Animal Cell Lines

This multi-volume set encompasses a substantial amount of research on fungal infections, emphasising relevant data in the discussion. It is intended to address the major causes of fungal biotechnological aspects while bringing in the most recent data concerning discoveries in livestock management. Each volume in the set will provide readers with the necessary information, complemented by the areas of focus outlined in the accompanying volumes. The set covers topics spanning from basic concepts to the health management to engineering using cell lines and approaching the bioprocess technology, with particular focus on recent developments. Volume 2 is a comprehensive resource on fungal infections, particularly in livestock management. It consolidates extensive research and data on these infections' causes and biotechnological aspects. The content spans from foundational knowledge to advanced topics such as health management and the application of cell line engineering. A significant focus is on bioprocess technology, reflecting the latest advancements in this area. This includes novel diagnostic techniques and emerging therapies that are reshaping the management of fungal diseases in animals. The book also explores current treatments ranging from established antifungal drugs to cutting-edge approaches like nanotechnology-based tools and immunotherapies. By providing a one-source repository of information, the book is a valuable tool for professionals in veterinary medicine, livestock management, and biotechnology research. It addresses the scientific community and offers practical insights for field applications, aiming to bridge the gap between research and real-world challenges in managing fungal infections in livestock.
Page Count:
368
Publication Date:
2025-12-22
ISBN-10:
3032064775
ISBN-13:
9783032064776
No comments yet. Be the first to share your thoughts!